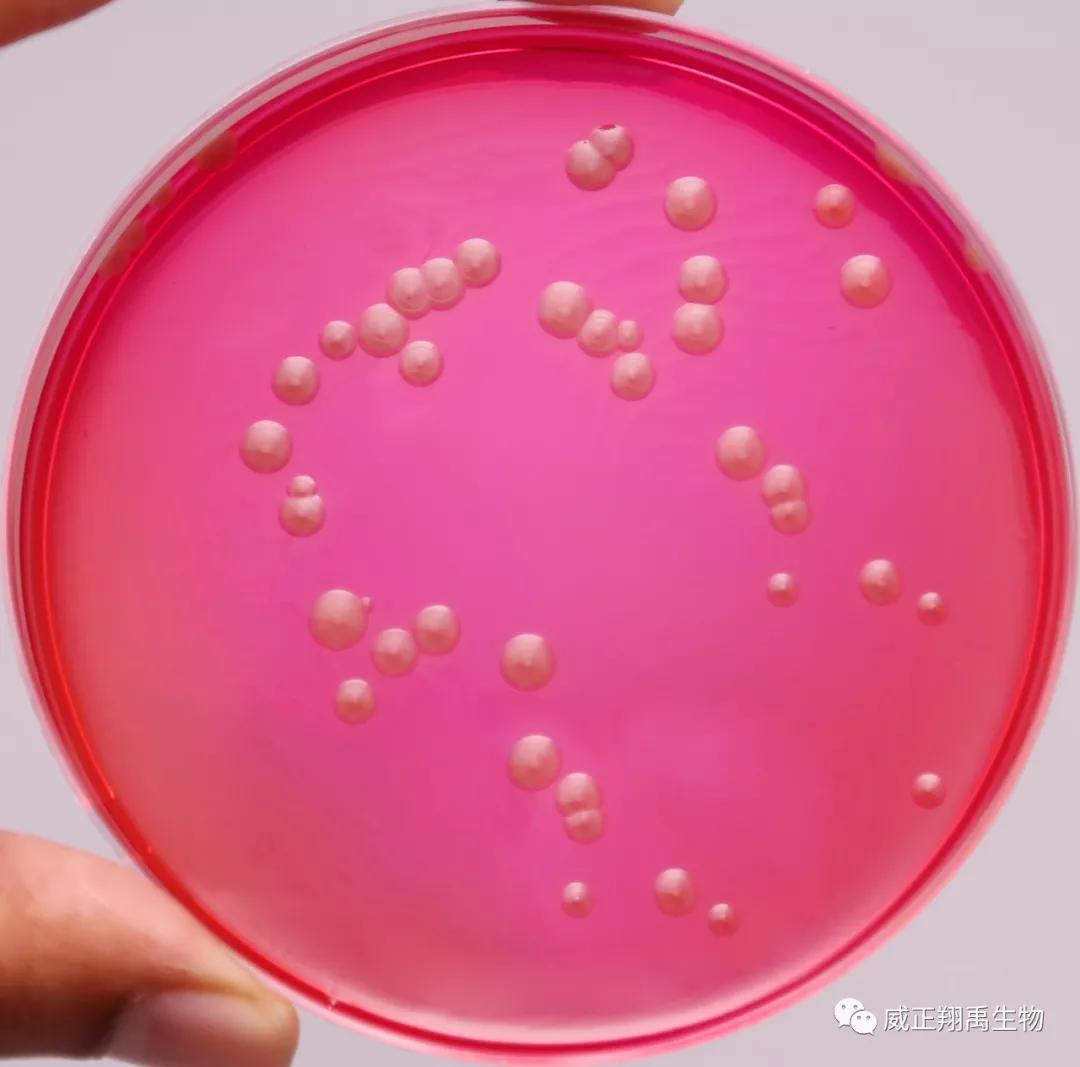
洋葱伯克霍尔德菌谁发现的,伯克霍尔德菌对洋葱有什么危害

近2年,『洋葱伯克霍尔德菌』被制药企业重视起来,因为发生过该菌对医用产品污染而导致患者严重感染的事件。
洋葱伯克霍尔德菌被FDA(美国食品药品监督管理局)看作是不可接受微生物,要求在制药企业中,针对非无菌药品进行普查。
那么,洋葱伯克霍尔德菌是一种什么样的细菌呢?
『洋葱伯克霍尔德菌』是一类过氧化氢酶阳性、不发酵乳糖的革兰氏阴性菌。
因为容易导致洋葱腐烂,最初被称为洋葱假单胞菌。1992年它被划归为一个独立的菌属。
实际上它有时又被称为洋葱伯克霍尔德菌复合体(Burkholderia Cepacia Complex),因为它是由大约15种至20种相近的物种组成(均为伯克霍尔德菌属)。
『洋葱伯克霍尔德菌』是一种条件致病菌,可引发包括肺炎、败血症、心内膜炎、伤口感染、脓肿在内的多种感染。
它最厉害的地方在于,它可形成生物膜,对消毒剂的抵抗力较强,在恶劣条件下也能生存,并对多种抗生素有很高的耐受性。因此一旦被感染,就不太容易治疗。
2019年12月1日,FDA(美国食品药品监督管理局)已在药典中新增一章《非无菌药品的检查——洋葱伯克霍尔德菌的检验》,并予以正式实施。我国在2020版药典中也将要新增洋葱伯克霍尔德菌的检查指标。
那么,应如何进行检查呢?
美国药典(USP)建议先用TSB肉汤进行增菌(30~35℃,48~72h)。
再用洋葱伯克霍尔德菌选择性琼脂培养基(简称BCSA)进行洋葱伯克霍尔德菌的分离。
美国药典(USP)指定了培养基中的四种成分——结晶紫、庆大霉素、万古霉素、多粘菌素B,用于抑制其他的微生物。
在培养基正式使用之前,也要对培养基进行生长促进等方面的适用性检查。
『洋葱伯克霍尔德菌』的分离
现在,世界知名微生物培养基生产商HiMedia公司推出了一款适合药厂使用的洋葱伯克霍尔德菌选择性培养基,符合美国药典的规定,具有很好的生长促进和分离功能。
产品信息
品名:洋葱伯克霍尔德菌选择性琼脂
英文:Burkholderia Cepacia Selective Agar(BCSA)
货号:M2089
规格:500g/瓶
品牌:HiMedia
配置
- 取50.6g BCSA干粉培养基,溶于1L蒸馏水,加热至沸腾使完全溶解。
- 高压灭菌(15磅 121℃ 15分钟)。冷却至45-50℃,混匀并倾注于无菌平皿。
- 制备好的培养基橙色透明至轻微不透明,pH值为6.90-7.10。
孵育条件
接种后在30-35℃孵育18-72h
质量控制
外观
淡黄色至粉色均匀可自由流动的粉末
成胶性
牢固,与1.4%琼脂凝胶相当
配好的培养基颜色和透明度
平皿内为橙色透明或轻微不透明凝胶
pH值
6.90-7.10
培养反应
30-35℃培养18-72小时,观察培养结果,确保达到如下标准
培养结果如下:

注:前四种菌株为USP指定菌株,用于培养基生长促进试验。
『洋葱伯克霍尔德菌』的鉴定
对分离的可疑菌落可使用非发酵菌生化鉴定试剂盒进行鉴定。
产品信息
品名:非发酵菌鉴定试剂盒(可鉴定洋葱伯克霍尔德菌)
英文:Hi24™ Nonfermenters Identification Kit
货号:KB019
规格:5KT/盒,10KT/盒,20KT/盒
品牌:HiMedia
操作
- 待鉴定菌种应先进行分离和纯化。
- 挑取单个可疑菌落,在5ml脑心浸膏肉汤35-37℃增菌4-6小时,直到在 620nm处接种液浊度≥0.1OD或0.5麦氏单位。
- 每孔接种50μl上述菌液。35℃-37℃孵育24-48小时。
- 依据结果诠释表和菌种标准表完成鉴定。
特点
- 实验结果准确、可靠。准确率在90%~99%。
- 操作简单,省时省力,无需仪器,无需编码,不必滴加石蜡油。
- 试剂盒含2种生化鉴定卡,分别含12种传统生化试验和12种糖发酵试验。可鉴定66种非发酵菌。
- 省心,所需试剂都包含在试剂盒中。
- 高效,一次孵育即出结果。

洋葱伯克霍尔德菌是药企产品和环境的不可接受微生物。采用洋葱伯克霍尔德菌选择性培养基和非发酵菌鉴定试剂盒可有效地对洋葱伯克霍尔德菌进行分离鉴定,值得大力推广。
HiMedia Laboratories公司是全球三大培养基生产厂家之一,是国际知名微生物产品生产商一直致力于微生物培养和鉴定产品的研发和生产,总部位于印度,有近50年的生产研发经验。它有3000多种产品,HiMedia公司的微生物培养基种类齐全、性价比高,具有WHO-GMP认证、ISO9001,ISO13485认证,CE和FDA注册登记。其产品已行销全球140多个国家。

思考题
1.洋葱伯克霍尔德菌被FDA(美国食品药品监督管理局)看作是不可接受微生物,要求在制药企业中,针对非无菌药品进行普查。如何进行检查呢?
2.对洋葱伯克霍尔德菌的分离和鉴定用到了HiMedia公司的哪两种产品,货号分别是?
编辑:田小翠
中国合作伙伴介绍

上海威正翔禹生物科技创办十多年来。
持续为国家重大科研项目提供高品质细胞培养用进口血清、培养基。
为实验室提供支原体预防和祛除的完整解决方案,
为生产、科研提供国际一线无血清培养基、无动物源性微生物培养基、蛋白胨、蛋白水解物产品。
十四年来,被生物界誉为值得“持续信赖的供货商”。
北京缔一生物是中国著名的Vian-Saga生物品牌旗下的销售公司,负责Ausbian、Minerva、HiMedia在中国境内所有产品的推广、销售、售后的总代理。
缔一生物的核心团队,均具有十几年生物领域的专业服务经验,专注于食品安全、微生物检测、细胞培养和工业发酵等领域。
为国内生产、科研用户提供原装进口的系列产品:细胞培养用牛血清、微生物培养基和检测试剂、支原体检测和祛除试剂、qPCR仪、自动核酸提取仪等。
往期精选

- 缔一生物全员到岗,共同战疫!
- 新型『无动物源』细胞培养基,疫苗生产专用!
- 『明串珠菌』培养——食品香气四溢的秘密!
- 快检『双歧杆菌』,只需四步!
- 【缔一生物】携手【HiMedia】国际品牌,世界制药原料展2019